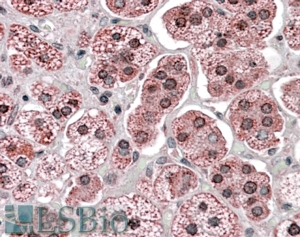

Formulation Supplied at 0.5 mg/ml in Tris saline, 0.02% sodium azide, pH7.3 with 0.5% bovine serum albumin.
| |
Unit Size 100 µg | |
Storage Instructions Aliquot and store at -20°C. Minimize freezing and thawing. | |
Synonym / Alias Names KPNA6|karyopherin alpha 6 (importin alpha 7)|FLJ11249|IPOA7|KPNA7|MGC17918|importin alpha 7 subunit|importin-alpha-S2|karyopherin alpha 6 | |
Accession ID NP_036448.1 | |
Blocking Peptide EBP08538 | |
Immunogen Peptide with sequence C-STTGESVITREMVE, from the internal of the protein sequence according to NP_036448.1. | |
Peptide Sequence C-STTGESVITREMVE | |
Purification Method Purified from goat serum by ammonium sulphate precipitation followed by antigen affinity chromatography using the immunizing peptide. | |
Shipping Instructions Refrigerated | |
Predicted Species Human, Mouse, Rat, Dog, Pig, Cow | |
Reactive Species Human | |
Human Gene ID 23633 | |
Mouse Gene ID 16650 | |
Rat Gene ID 362607 | |
Product Grade ![]() | |
IHC Results In paraffin embedded Human Adrenal Gland shows staining of cytoplasm and some nuclear membrane (nuclear pores). Recommended concentration, 3-6µg/ml. | |
ELISA Detection Limit Antibody detection limit dilution 1:128000. | |
Western Blot Approx 60kDa band observed in Human Skeletal Muscle lysates (calculated MW of 60.0kDa according to NP_036448.1). Recommended concentration:0.1-0.3µg/ml.
Some minor background is detected and is blocked by the immunizing peptide. We call for caution when used for other assays than Western blot. | |
Application Type Pep-ELISA, WB, IHC |
Goat Anti-KPNA6 Antibody
$431.00
| SKU | Unit Size | Price |
|---|---|---|
Select a unit size:
Documents |